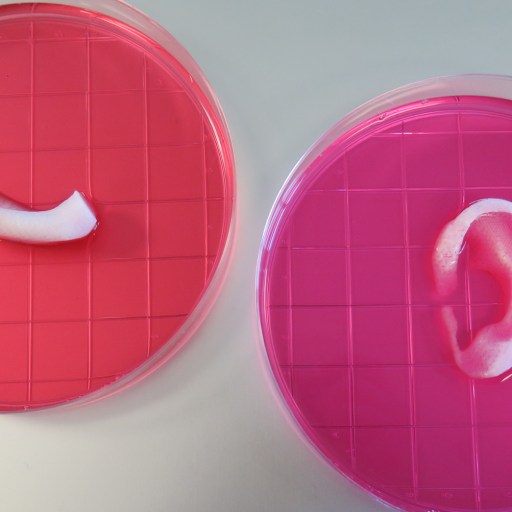

Search
Natalie Shoemaker
Contributing Writer
Natalie has been writing professionally for about 6 years. After graduating from Ithaca College with a degree in Feature Writing, she snagged a job at PCMag.com where she had the opportunity to review all the latest consumer gadgets. Since then she has become a writer for hire, freelancing for various websites. In her spare time, you may find her riding her motorcycle, reading YA novels, hiking, or playing video games. Follow her on Twitter: @nat_schumaker
Read Less

The search for Planet Nine is on. The problem is scientists don't know where to start — it has an orbit of 10,000 to 20,000 years. However, a group of researchers from France may have narrowed the search area.

NASA has teamed up with the International Potato Center (CIP) in an effort to find out if the potato will be part of the Mars mission.

The coffee pod design isn't sustainable, so the German city of Hamburg has placed a ban on government-run buildings from using “Kaffeekapselmaschine,” or coffee capsule machines.

ReWalk announced a commercial health program that will provide coverage for a personal exoskeleton system. The beneficiary of this ReWalk exoskeleton is a surgeon who has been bound to a manual wheelchair for 11 hours a day at work.

Exercise has a number of health benefits for both brain and body. Researchers from the Academy of Finland wanted to find out what kind of exercises provide the best workout for the brain.

Around 53 million years ago, the Arctic was host to a wide range of creatures that thrived in its warm swamps. The fossil record shows how our warming climate might influence old migratory patterns to reemerge in the Arctic Circle.

Google CEO Sundar Pichai announced he's standing with Tim Cook and Apple's decision. He agreed that complying with the FBI order to create a backdoor for the iPhone would set a dangerous precedent.

The FBI has ordered Apple to create a special version of its software that would remove a security feature, providing investigators with a backdoor to unlock the iPhone through “brute force” methods. Did we mention this iPhone belongs to a terrorist?

The U.S. wind industry saw huge growth in 2015. The American Wind Energy Association announced this week that the industry installed more wind power than any other electric source.

Amphibians are disappearing across the world — species are becoming extinct thanks to a fungus spread through human disruption. The Book of Frogs, by biologist Timothy Halliday, commemorates these creatures, which soon may slip into the pages of history.
The Integrated Tissue and Organ Printing System may be the future of organ replacement. For the first time, scientists have successfully produced and attached functional pieces of human tissue made of living cells.

Repeating myths in order to correct them can backfire, causing people to remember the myth as fact, and forgetting the fact altogether. Researchers suggest other ways for journalists to correct misinformation.

China, India, Brazil, and Indonesia are the biggest carbon emitters. They also have the highest rates of premature deaths from air pollution.

Since the dawn of automation, robots have been taking human jobs. But a short period of unemployment has always been followed by new kinds of jobs to offset this loss. This scenario may not be the case in the future.

Robots could be considered legal drivers in the United States. This means human occupants inside the vehicle wouldn't require a valid license in order to ride inside — the software would be the vehicle's legal “driver.”

Every year, air travel contributes more and more carbon emissions into the atmosphere, altering the world's climate. But we never stop to think about how climate change will affect air travel. Paul Williams, an atmospheric scientist at the University of Reading, is about to tell us.

Some disability-access points across America are getting a makeover. The signs now feature a person active and engaged. This change in imagery is part of a larger initiative called the “Accessible Icon Project.”

Earth may have suffered a violent impact from a "planetary embryo" called Theia 4.5 billion years ago. This impact allowed the moon to form. But new research suggests Theia also became a part of Earth.

France has introduced a law banning supermarkets from disposing of quality, unsold food approaching its best-before date. It will help reduce the amount of food waste the country produces while also helping feed the country's poor.
